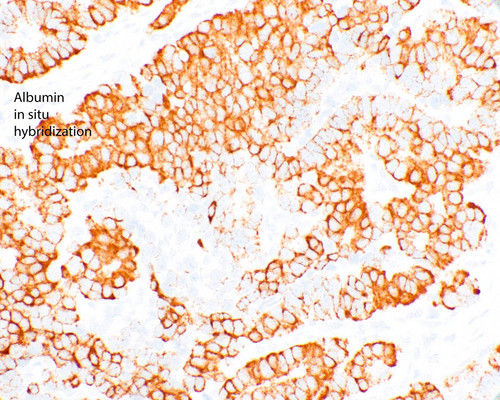
GwAbac9XcAA3dSu.jpg

- Menu
-
EN
- Afrikaans
- Azərbaycan
- Bosanski
- Català
- Cymraeg
- Dansk
- Deutsch
- Eesti
- English
- Español
- Español (Mexican Spanish)
- Euskara
- Filipino
- Français
- Hausa
- Hrvatski
- Igbo
- Indonesia
- Italiano
- Kiswahili
- Kurdî (Kurmancî)
- Latviešu
- Lietuvių
- Magyar
- Melayu
- Nederlands
- Norsk
- O‘zbek
- Polski
- Português
- Português (Brazilian Portuguese)
- Română
- Slovenčina
- Slovenščina
- Srpski
- Suomi
- Svenska
- Tagalog
- Tiếng Việt
- Türkmen Dili
- Türkçe
- Èdè Yorùbá
- Íslenska
- Čeština
- Ελληνικά
- Български
- Македонски
- Монгол
- Русский
- Српски
- Українська
- Қазақ Тілі
- Հայերեն
- עברית
- اردو
- العربية
- فارسی
- پښتو
- کوردیی ناوەندی
- नेपाली
- मराठी
- हिन्दी
- বাংলা
- ਪੰਜਾਬੀ
- ગુજરાતી
- தமிழ்
- తెలుగు
- ไทย
- မြန်မာ
- ქართული
- አማርኛ
- 中文
- 中文 (Traditional Chinese)
- 日本語
- 한국어
- Explore
- Upload
- Sign in
- Create account